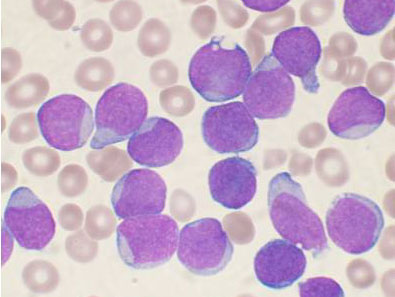

中國科學家發現新的白血病抑癌基因
發布時間:2014/2/12 9:48:39
我國科學家近期主導研究發現了一個在急性白血病病人中有較常見突變的抑癌基因,且揭示其功能異常與多種不同致癌基因之間的協同作用,因而為研發白血病新的治療方法提供了重要基礎。這項最新成果10日在國際著名學術期刊《自然-遺傳學》(NatureGenetics)上發表。
該研究是在國家自然科學基金委、科技部、中科院以及天津市科委多個重點基金資助下,由中國醫學科學院血液學研究所教授程濤、竺曉凡和中國科學院北京基因組研究所研究員王前飛等率領的多個團隊合作完成的。
程濤等人通過對一個混合譜系白血病(MLL)患者及其正常同卵雙胞胎的血細胞進行全基因組測序,發現了罕見的功能性MLL-NRIP3致癌基因和H3K36三甲基化的組蛋白甲基轉移酶SETD2的遺傳突變。
程濤表示,MLL白血病發生率占嬰兒白血病的70%、急性髓系白血病的10%以上,帶有MLL重排基因的病人預后差別較大。通常認為這與除MLL融合基因以外的變異基因有較大關系。該研究表明SETD2是白血病的新抑癌基因,而且SETD2-H3K36me3通路的功能破壞是白血病發生發展的一種新的表觀遺傳機制。
程濤指出,當前癌癥研究的主要挑戰之一就是多種致癌基因或機制如何協同導致細胞惡變。他們的發現將促進對白血病乃至其它癌癥發病機制的認識,有助于臨床藥物開發。

下一篇:我國將做好疫苗審批上市準備
相關閱讀
- T細胞療法可將癌癥患者的生存期延長數年2014-12-31
- 吞噬可抑制APL細胞促凝和纖溶活性2011-12-08
- 《科學》:抑癌基因BRCA1抑制腫瘤有新方式2011-11-07






